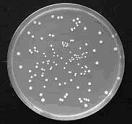
從葡萄汁中分離出不同菌種

94年1月(第151期)
釀酒用酵母菌的篩選與鑑定
一、前言
酵母菌在釀酒、食品與醫療工業上扮演重要的角色,酵母菌含有豐富的蛋白質、維生素等養分,可以提取輔酶A、細胞色素C、腺核苷三磷酸 (ATP) 等生化原料產品,也可以利用酵母菌來生產維生素、胺基酸或有機酸等代謝產物,當然,最重要且普遍的用途之一是釀酒。相傳在神農時代,中國人的祖先就懂得種植黍、稷、稻、麥、菽等五穀利用酒麴來造酒,文獻上也曾記載大禹時代夷狄造酒,可見得我們的祖先很早就知道如何利用酵母菌等微生物進行釀造。
二、釀酒酵母菌的應用與篩選
釀酒的酵母菌學名為Saccharomyces cerevisiae,意思是吃糖的菌,cerevisiae在拉丁文中意為發酵,顧名思義,酵母菌最喜歡的食物就是各式各樣的糖類,包括蔗糖、果糖、葡萄糖、麥芽糖等。因此在含糖分較高的水果表面、花粉、花蜜、蔬菜上常常可以尋獲,在葡萄的果皮表面也有很多的酵母菌,這就是葡萄可以自然發酵變成葡萄美酒的原因。雖然酵母菌有很長的名字,但是酵母菌卻是極小的生物,只能在顯微鏡下觀察,估計約200億個酵母菌細胞才重約一公克。天然酵母菌在自然界分布很廣,近年來各國食品界興起了一股尋找各式天然酵母菌的風潮,從野花、漿果等不同來源植物分離純化酵母菌,並測試這些酵母菌進行麵包製作或釀酒的風味,就是為了能發展出特殊的產品。
 |
 |
|
圖1 田間栽培的葡萄表面存在各種酵母菌種(左),破碎去梗榨汁後(中),可以從葡萄汁中分離出不同菌種(右)。
三、酵母菌的鑑定
天然酵母菌曾被人類觀察記載的種類據統計約有七百多種,未曾被觀察發現的種類則估計超過數十萬種,傳統鑑定酵母菌的方法必須綜合形態特徵、芽孢分生方式、生化鑑定或是由不同的篩選培養基區分,且需要豐富的經驗。在分子生物學興起之後,由分子層次進行酵母菌分子標誌分析輔以傳統分類學方法進行鑑定已經成為主流。
(一)核糖體基因序列鑑定法
在分子層次的鑑定方法中,利用聚合酶連鎖反應(polymerase chain reaction, PCR)擴大複製核糖體基因(ribosomal DNA)的內轉錄間隔區(Internal transcribed spacer, ITS)是最常被使用的方法。核糖體基因為一呈縱線排列頭尾相連的重複性基因,每個重複單元包含了小次單元(16-18 S)、大次單元(23-28 S)及5.8 S基因(如圖2),這些解碼區(coding region)被內轉錄間隔區ITS隔開。大、小次單元由外間隔區(External spacer)或稱基因間隔區區隔(Inter-genic spacer, IGS),5.8S基因則位於內轉錄間隔區中。由於身兼細胞中所有蛋白質生合成的任務,核糖體基因在不同物種間的演化相當保守(conservation)且在基因組中數量豐富,因此常被用來鑑別不同種的微生物。

圖2 核糖體基因結構圖
科學家很早就發現,不同的酵母菌種其ITS片段大小有所差異,從約400到800鹼基對(base pair)都有,因此由PCR擴大複製ITS序列後,由長度便可初步區分酵母菌可能的種類(圖3)。接著可以利用限制酶對ITS序列作進一步辨識,如果基因序列呈現變化,所切出來的片段大小也有所不同(圖4)。 圖3 由ITS長度可先區分酵母菌種類 圖4 利用限制酶Hinf I(上)與Hae III(下)可以將ITS切成八種不同大小片段型式。

圖3 由ITS長度可先區分酵母菌種類

圖4 利用限制酶Hinf I(上)與Hae III(下)可以將ITS切成八種不同大小片段型式
上述的鑑別工具相當簡便,在一天內就可以完成,然而片段大小的資訊終究有限,面對眾多的未知菌種,需要更豐富的資訊來作進一步確認。在圖5中顯示了六種葡萄表面酵母菌的ITS部分序列,其中Major是葡萄發酵七天後僅存的酵母菌,也就是Saccharomyces cerevisiae,在發酵過程中因為產生高量的酒精,使其他酵母菌因為不耐酒精而紛紛死亡,最後主宰了發酵過程。其他1到5的菌種分別是Candida bombi、C. stellata CBS 157、Starmerella aff. bombicola JJ-14、C. cf. stellata 10-372、C. zemplinina EJ1,其中C. bombi和C. stellata為同屬不同種,從ITS片段長短以及限制酶分析都無法區分,但是進行定序之後,可以看出這兩個菌種有相當大的差異(圖5中編號1及2),顯示出基因序列豐富的資訊價值。

圖5 不同種酵母菌的ITS序列資訊,進行序列比對後可以發現歧異大及保守的區域,有豐富的資訊價值
(二)其他分子鑑定法
但即使將ITS序列完全解出,面對眾多的商業酵母菌,ITS序列仍有不足之處,粒線體基因是另一個可用之工具。粒線體是生物細胞中負責代謝養分產生能量的胞器,有自己獨立的基因組,可以將細胞破碎後離心分離出粒線體,再抽取全部基因利用限制酶切碎電泳比較。酵母菌的粒線體基因組大小約85Kb,利用限制酶分析酵母菌S. cerevisiae之粒線體片段長度多型性,可以看出不同商業酵母菌菌系之間的差異。圖6為自食品工業研究所購買供測之8種S. cerevisiae商業酵母菌菌系(Lane1-8),分別是(1) Cote des blancs, Red Star、(2) Pasteur champagne, Red Star、(3) Flor sherry, Red Star、(4) Montrachet, Red Star、(5)Sauvigonon, DSM、(6) L-2226, Lalvin、(7) KL-1116, Lalvin、(8) RC212, Lalvin。
其他可以利用的分子鑑定工具包括常見的微衛星體序列大小(SSR)、擴大複製片段長度多型性(AFLP)、逢機複製片段長度多型性(RAPD)等技術,因限於篇幅無法一一介紹,可以確定的是由於分子生物學的進展,大幅拓展了傳統生物學的研發應用領域。

圖6 同樣的發酵用菌種S. cerevisiae,不同商業品系可以用粒線體基因限制片段長度多型性來分析
四、結語
台灣在加入WTO後正式結束菸酒專賣制度,鑑於921地震對中部地區造成極大的災情,政府為了輔導災區產業重建,於89年就災區先行開放水果釀酒事業,並於91年訂定「農村酒莊輔導作業要點」,目前農委會所屬研究機關也積極研發釀酒技術,並篩選本土天然菌種以期能為酒莊產業發展奠定良好基礎,相信國人的智慧與努力必可為國內酒莊及相關水果產業開創另一番成就。 圖5 不同種酵母菌的ITS序列資訊,進行序列比對後可以發現歧異大及保守的區域,有豐富的資訊價值 圖6 同樣的發酵用菌種S. cerevisiae,不同商業品系可以用粒線體基因限制片段長度多型性來分析。

